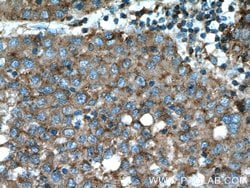

Promotional price valid on web orders only. Your contract pricing may differ. Interested in signing up for a dedicated account number?
Learn More
Learn More
Beta galactosidase Rabbit anti-Human, Mouse, Polyclonal, Proteintech


Rabbit Polyclonal Antibody
Supplier: Proteintech Group Inc 155181AP150UL

Description
GLB1 cleaves beta-linked terminal galactosyl residues from gangliosides, glycoproteins, and glycosaminoglycans. Isoform 2 has no beta-galactosidase catalytic activity, but plays functional roles in the formation of extracellular elastic fibers (elastogenesis) and in the development of connective tissue. This protein seems to be identical to the elastin-binding protein (EBP), a major component of the non-integrin cell surface receptor expressed on fibroblasts, smooth muscle cells, chondroblasts, leukocytes, and certain cancer cell types. In elastin producing cells, associates with tropoelastin intracellularly and functions as a recycling molecular chaperone which facilitates the secretions of tropoelastin and its assembly into elastic fibers.Specifications
| Beta galactosidase | |
| Polyclonal | |
| Unconjugated | |
| GLB1 | |
| Acid beta galactosidase, Beta galactosidase, EBP, Elastin receptor 1, ELNR1, galactosidase, beta 1, GLB1, Lactase | |
| Rabbit | |
| Antigen Affinity Chromatography | |
| RUO | |
| 12091, 2720 | |
| -20°C | |
| Liquid |
| Immunocytochemistry, Immunofluorescence, Immunohistochemistry (Paraffin), Western Blot | |
| 0.19 mg/mL | |
| PBS with 50% glycerol and 0.02% sodium azide; pH 7.3 | |
| P16278, P23780 | |
| Glb1 | |
| Beta galactosidase Fusion Protein Ag7792 | |
| 150 μL | |
| Primary | |
| Human, Mouse | |
| Antibody | |
| IgG |
Product Content Correction
The Fisher Scientific Encompass Program offers items which are not part of our distribution portfolio. These products typically do not have pictures or detailed descriptions. However, we are committed to improving your shopping experience. Please use the form below to provide feedback related to the content on this product.
Product Title
Spot an opportunity for improvement?Share a Content Correction